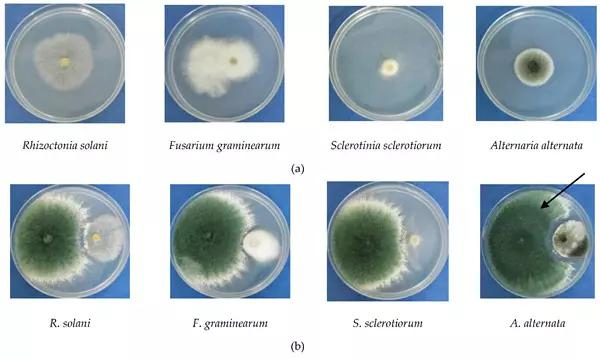
Bio Fungicide Fertilizer Trichoderma Asperellum 10 Billion Cfu/G Against Bacterial Pathogens

Product Introduction
Trichoderma asperellum is a species of fungi in the family Hypocreaceae, works as biological control agent for protecting plants from plant pathogenic fungi, including Fusarium, Rhizoctonia, Sclerotinia, and Pythium. The antifungal powder can inhibit the growth of plant diseases by producing enzymes that break down their cell walls.
Composition & Specifications:
• Bacteria count: 1x 10^10 cfu/g, 2 x 10^10 cfu/g, 4 x 10^10 cfu/g
• Active Ingredient: Trichoderma asperellum strain
• Formulation: Wettable Powder and Granular type available
Target Diseases
- Fusarium wilt (Fusarium oxyporum)
- White rot (Sclerotinia cepivorum)
- Damping off (Pythium aphanidermatum / Rhizoctonia solani)
- Root rot (Macrophomina Phaesolina)
- Grey mould (Botrytis cinerea)
Antagonistic Activity

Mode of Action
Competition: Spreads quickly in the root zone to exclude harmful microorganisms.
Growth promotion: Enhances plant nutrient uptake and vigor.
Antibiosis: Produces antibiotic metabolites to inhibit pathogens.
Mycoparasitism: Parasitizes pathogen sclerotia and hyphae resulting in lysis.
Application Methods
Soil Drench: 1-2 kg per acre mixed with water.
Soil Treatment: Mix 2 kg with 20 kg organic manure per acre.
Seedling Root Dip: Mix 2 kg with 50L water; dip for 10 mins.
Seed Treatment: 40g per 1kg of seeds.
Frequently Asked Questions
Can I get a free sample?
Yes, 20-50 gram free samples can be provided with freight collect.
What is the Minimum Order Quantity (MOQ)?
For sample testing, the MOQ is 1 kg. For commercial orders, the MOQ is 100 kgs.
Can you provide documents for registration?
Yes, we can support distributors with the necessary documentation for local registration.
What are the available payment terms?
We accept T/T Bank wire, LC at sight, Paypal, Payoneer, and Alipay.
What is the typical delivery time?
Usually about 10-20 days, depending on the specific quantity and product type.
Do you offer neutral packing or re-labeling?
Yes, neutral packing and re-label services can be provided upon request.